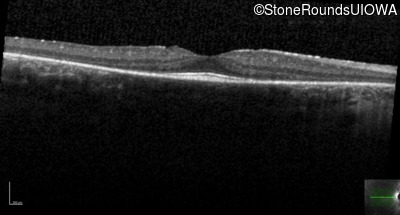
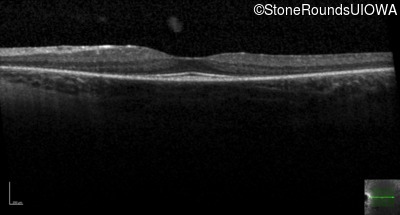
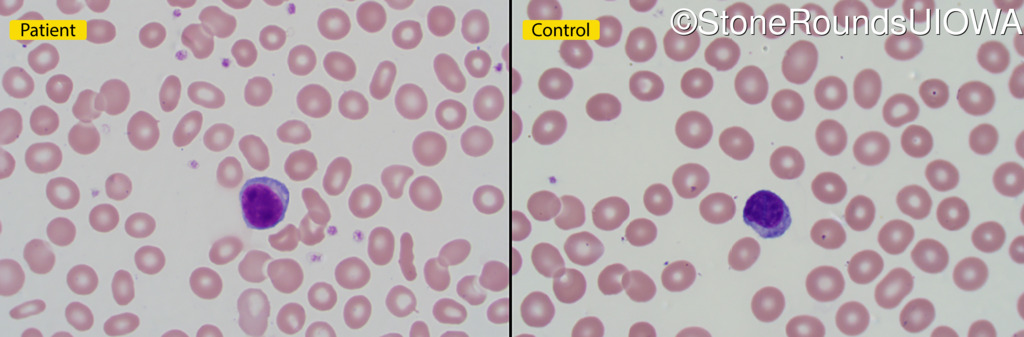

Case
SR389
Student Mode
Retinitis Pigmentosa with Anemia (IB10)
Male
Male
Hidden
SR389
Student Mode
Retinitis Pigmentosa with Anemia (IB10)
Male
Male
History
This 19 year old man experienced periodic high fever as a child. He had no difficulties with his vision until age 19 when some abnormal pigmentation was incidentally discovered or routine fundus examination.
| Color Vision: | Correctly identified 11/14 Ishihara pseudoisochromatic plates with the right eye and 12/14 with the left eye. |
|---|---|
| Refraction OD: | -3.75 +0.75 x 145 |
| Refraction OS: | -3.00 +0.75 x 40 |
Teaching Points
The clinical features favoring the diagnosis of retinitis pigmentosa with anisocytosis include: childhood onset periodic fever; mild anemia; anisocytosis on peripheral blood smear; night blindness and constricted visual fields as his earliest visual symptoms; bone-spicule-like pigmentation and narrowed arterioles on fundus examination; loss of outer retinal structures on OCT; and, normally sighted parents.
| Age at visit: 19 years |
Diagnosis & molecular findings
| Disease | Gene | Allele 1 variant(s) | Allele 2 variant(s) | Inheritance mode |
|---|---|---|---|---|
| Retinitis Pigmentosa with Anemia | TRNT1 | Thr42 del3acAGA | Lys416 del1tggA | AR |
Disease:
Gene:
Allele 1:
Thr42 del3acAGA
Allele 2:
Lys416 del1tggA
Inheritance:
AR